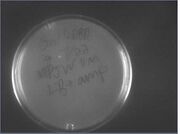
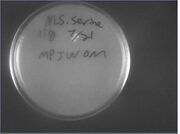
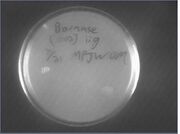
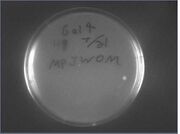

Uploads by Lu Wang
From OpenWetWare
Jump to navigationJump to search
This special page shows all uploaded files.
| Date | Name | Thumbnail | Size | Description |
|---|---|---|---|---|
| 15:17, 12 August 2010 | V9 v10 ep digest.jpg (file) |  |
11 KB | |
| 18:19, 3 August 2010 | Simple flowchart.jpg (file) |  |
34 KB | |
| 17:25, 23 July 2010 | NLS.Serine Lig 7-22.jpg (file) |  |
13 KB | |
| 17:25, 23 July 2010 | B21 Lig 7-22.jpg (file) |  |
13 KB | |
| 17:24, 23 July 2010 | GalDBD Lig 7-22.jpg (file) | |
13 KB | |
| 17:22, 23 July 2010 | Barnase (1002) lig 7-22.jpg (file) |  |
13 KB | |
| 17:15, 23 July 2010 | NLS.Serine lig 7-21.jpg (file) | |
13 KB | |
| 17:14, 23 July 2010 | Barnase Ligation 07-23.jpg (file) | |
14 KB | |
| 17:12, 23 July 2010 | GalDBD lig 7-21.jpg (file) | |
13 KB | |
| 17:11, 23 July 2010 | B21 Lig 7-21.jpg (file) |  |
13 KB | |
| 17:08, 23 July 2010 | NLS.Serine Lig 7-19.jpg (file) |  |
13 KB | |
| 17:07, 23 July 2010 | B21 lig 7-19.jpg (file) |  |
13 KB | |
| 17:03, 23 July 2010 | 5xGalpt Lig 7-19.jpg (file) |  |
13 KB | |
| 16:14, 23 July 2010 | Antisense cut w X P.jpg (file) |  |
11 KB | |
| 21:04, 22 July 2010 | Summer Flowchart.svg (file) | Error creating thumbnail: convert-im6.q16: non-conforming drawing primitive definition `stroke-dasharray' @ error/draw.c/RenderMVGContent/4456.
|
61 KB | first version, up to biobrick vector w all three parts |
| 21:03, 22 July 2010 | TeamAllergyFlowChart.png (file) |  |
62 KB | First version, up to biobrick |
| 21:23, 16 July 2010 | AmiRNA d digest.jpg (file) |  |
155 KB | 7/16 diagnostic digest of the miniprep we did earlier this morning. will be sent off for sequencing |
| 21:17, 8 July 2010 | Allergen Panel after 40 min.jpg (file) |  |
12 KB | same gel, 10 mins later |
| 21:07, 8 July 2010 | Betv2 s, Betv2 A, Ger A.jpg (file) |  |
12 KB | second of two images |
| 21:06, 8 July 2010 | LTP A,Bet1 A, Bet2 S Gel.jpg (file) |  |
12 KB | first of two images |
| 18:32, 23 June 2010 | 550.jpg (file) |  |
133 KB | Ariana and I at a ballroom competition |